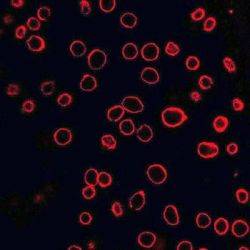
Nanovýbuchy dostanú lieky do buniek

Chemické "nanovýbuchy", vyvolané laserovým zohriatím nanočastíc, dokážu vytvoriť dočasné dierky v bunkových membránach, cez ktoré stihnú preniknúť priamo do buniek liečivé malé molekuly, bielkoviny a upravená DNA. V časopise Nature Nanotechnology to predbežne online oznámil štvorčlenný tím, ktorý viedol Mark Prausnitz z Georgijského technologického inštitútu v Atlante (USA). Prvou autorkou článku bola jeho kolegyňa Prerona Chakravartyová. Podstata nového prístupu spočíva v netradičnom využití uhlíkových nanočastíc. Po aktivácii laserovým svetlom vybuchujú, čím sa v membránach blízkych buniek otvárajú malé dierky, práve na dostatočne dlhý čas, aby sa z tekutej zložky predmetného tkaniva do buniek dostali liečivé látky. Vedci vyladením tohto laserového pôsobenia dostali markérové molekuly až do 90 percent cieľových molekúl, z ktorých tento zásah prežilo tiež zhruba 90 percent.
"Táto metóda by nám mohla dovoliť dodávku pestrej palety liečivých prostriedkov, ktoré v súčasnosti neprenikajú do buniek ľahko. Jedným z najvýznamnejších perspektívnych využití je oblasť génovej liečby, ktorá sa v medicíne javí ako veľmi sľubná, no jej pokrok obmedzujú problémy s dodávkou DNA a RNA do buniek," povedal Mark Prausnitz. Dosiaľ sa to robilo prostredníctvom upravených vírusov, "poťahovaním" DNA či RNA špecifickými chemikáliami a využívaním elektrických polí respektíve ultrazvuku. Spoločný cieľ: pootvoriť bunkové membrány. Všetky tieto spôsoby však majú slabé miesta, buď nie sú dosť efektívne, alebo vyvolávajú obavy o zdravotnú bezpečnosť.
Tím Marka Prausnitza sa ako prvý pokúsil nasadiť v tejto súvislosti tepelnú aktiváciu reaktívnych uhlíkových nanočastíc. Inšpirovali ich skoršie výskumy tzv. fotoakustického efektu čiže svetlom vyvolanej zmeny tlaku. Priemer použitých častíc bol iba 25 nanometrov (miliardtín metra). Častice vložili do tekutiny okolo cieľových buniek. Následne na ne pôsobili femtosekundovými impulzmi (femto = tisícbilióntina) laseru, ktorého pracovná vlnová dĺžka spadala do oblasti blízkeho infračerveného svetla. Častice tieto svetelné impulzy pohlcovali a zohrievali sa. Okolitú tekutinu tým menili na paru, ktorá s nimi reagovala na vodík a oxid uhoľnatý. Z týchto plynov vznikali zväčšujúce sa bublinky, ktoré po prerušení prísunu energie z impulzu pukali – vznikla rázová vlna, ktorá narobila dierky v membránach blízkych buniek. Tie sa síce zasa rýchlo uzavreli činnosťou bunkových opravných mechanizmov, no markéry medzitým prenikli do vnútra.
Podarilo sa to s tromi typmi markérov – malou molekulou calceínom, bielkovinou albumínom z kravského séra a napokon s DNA v podobe plazmidu (neveľký útvar genetického materiálu pod úrovňou chromozómu). Cieľmi boli bunky ľudskej rakoviny prostaty a potkanie bunky gliosarkómu (vzácny typ mozgovej rakoviny). Pokusy potvrdili, že takto do buniek dopravená DNA si zachovala funkčnosť čiže riadila tvorbu bielkovín. Ukázal to plazmid, ktorý kódoval svetielkujúcu bielkovinu luciferázu. Jej tvorba v bunke po zavedení plazmidu sedemnásťkrát stúpla.
Zdroj: Komuniké Georgia Institute of Technology z 27.7.2010
Autor článku: TASR